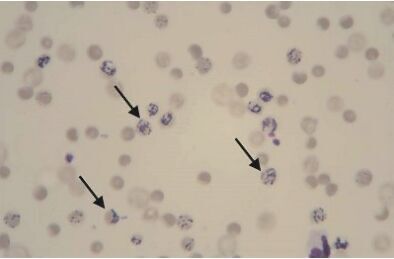
683bc4ea2fac1.jpg

13.下列何種動物之血液抹片中,最常見斑點型(punctate type)和聚集型(aggregate type)之網織球
(reticulocyte)?
(A)豬
(B)犬
(C)牛
(D)貓
答案:登入後查看
統計: A(33), B(6), C(35), D(709), E(0) #3280903
統計: A(33), B(6), C(35), D(709), E(0) #3280903
詳解 (共 3 筆)
#6449876
Reticulocyte
可用 new methylene blue stain(新亞甲基藍) 或
brilliant cresyl-blue(煌酚藍)染色 (要背!)
馬血中無網狀球!只有成熟的紅血球才會進入末梢血液
貓的網織球分為兩種
1. 聚集型 ( aggregate type ):狗的也是這種
壽命12小時,和其他家畜的網織球相似,可作為急性嚴重出血之骨髓反應評估,佔(0.4%)
2. 班點型 ( punctate type ):壽命10~12天,比聚集型更成熟,輕度貧血評估可以測此型,佔(10%)
前人記憶法:
聚集型0.4%: 聚4(巨噬)但要記得是0.4
斑點型10%:10斑(石斑魚)
無核網狀球之細胞質中,還是有少量RNA聚集,所以使用新甲烯基藍(NMB)時,可見藍色網狀物=網狀球(reticulocyte)
用Romanowsky型染色劑時,網狀球通常呈現多染色性,或偶含有偏一側之核殘餘物,稱之爲賀邱氏小體(Howell-Jollybodies )

14
0